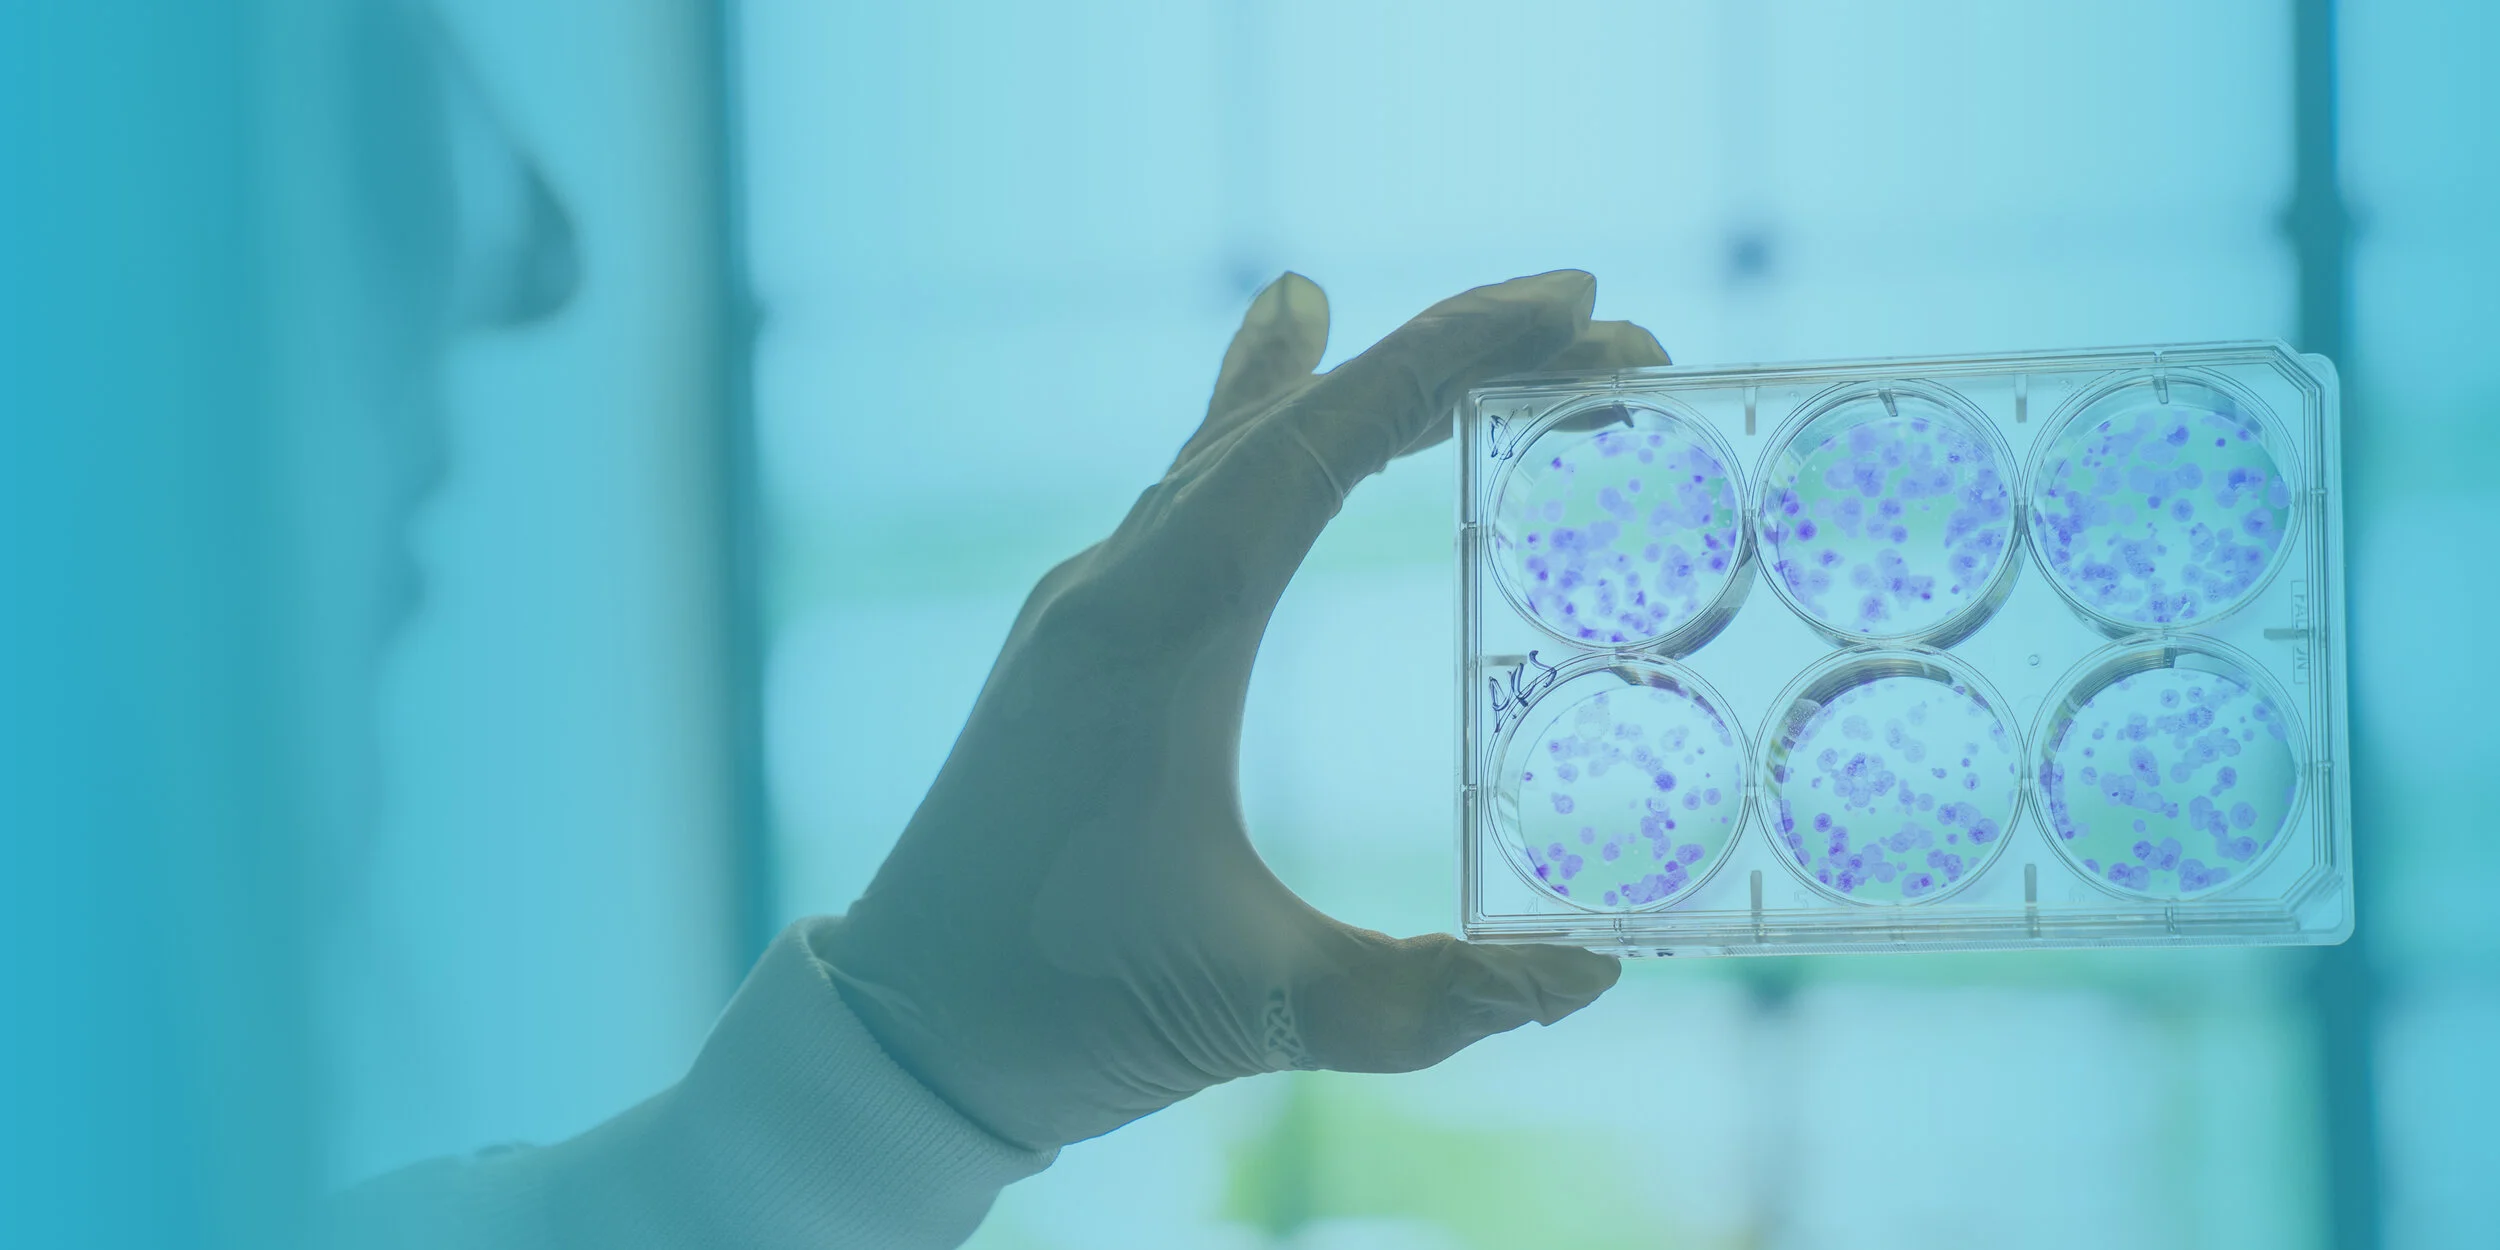

WE’VE ALWAYS BEEN READY
Creating a world that pairs voice over, beautiful visuals, and singular subject characteristics that will enhance the viewer’s quick glimpse into the Mass General world, leaving them to say, ‘wow’ and ‘what can I do to be a part of this?’
“Nobility Worn Lightly”
OUR INTENtION
This video is a reminder of what it means to be a part of the Mass General community. To highlight dedication and commitment; it’s because of this, the contribution of every single individual, that sets Massachusetts General Hospital apart. This video will excite and ignite enthusiasm, leave people with a sense of pride, a reminder of what it means to be part of the Mass General family.
INSPIRATION VIDEO
The below video is how we want this video to look and feel. We want to make the viewer come away with a sense of awe, pride, but most importantly - an urge to act.
VOICE-OVER
We meet at the crossroads of challenges and discovery.
And drive onward - through 200 years of possibility.
In pursuit of a grander question … What does it mean to leave an impact on mankind?
What does it mean to always be ready?
When every life counts, seconds, minutes, hours make the difference. We are creating revolutionary results.
We’re not starting from the beginning; here we stand, continuously building on the foundation of bold breakthroughs set before us. By pioneers — paving the way towards a future of compassionate care.
An evolution rooted in care, research, community. While guiding the next generation of dedicated leaders.
We have always been ready.
At Mass General, we’re after the lifelong pursuit. Those dedicated do not step in for the moment, they are committed for life.
Here stand the ambitious, the relentless, the risk takers and the visionaries. The resolute and the fierce.
All who will leave a legacy in place for the trailblazers of tomorrow.
Together, we will always be ready.
MUSIC
GOAL
How do we leave an impression, become a memory? As we are carried by an inspiring voice over, there is something that can be said through visuals that conveys a moment better than words ever could. We can feel an emotion and we react to these connection.
Combining these two styles, we create a video that is celebrated during the event and beyond. We leave our audience wanting more, yearning to be a part of it all.
VISUAL APPROACH
BOLD BREAKTHROUGHS
Capturing imagery showing the state-of-the-art facilities and driven medical researchers.
COMPASSIONATE CARE
Highlighting patient care and communities by revealing visuals of everyday hospital staff, nurses, and the communities they love and serve.
REVOLUTIONARY RESULTS
Visionaries: focusing on the ones behind the science, care, approach. From doctors to staff, providers and researchers; history is redefined by the visionaries.